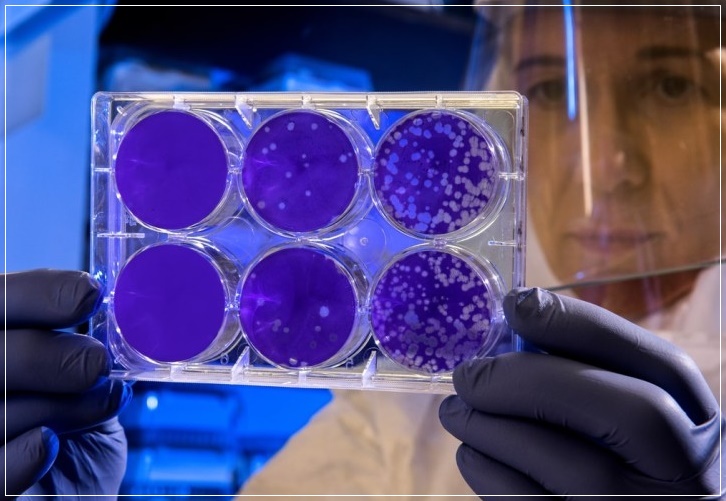

오스트레일리아의 과학자들이 중국 우한에서 시작된 ‘신종 코로나바이러스’를 성공적으로 복제해냈습니다. 신종 코로나바이러스 복제 성공으로 무증상 감염자들을 식별해내는데 획기적 도움이 될 것이라는 기대가 높아지고 있습니다.
오스트레일리아 멜버른의 도허티 연구소가 신종 코로나바이러스 배양에 성공했다고 <아에프페>(AFP) 통신 등이 29일 보도했습니다. 마이크 캐턴 박사가 이끄는 연구진은 감염된 환자의 몸에서 빼낸 신종 코러나바이러스를 지난 24일 전달받아 실험실에서 이를 본떠 키우는 데 성공했다는 것입니다. BBC 방송은 세계보건기구(WHO)와 관련 정부를 공유하게 되면 바이러스 진단과 치료에 많은 도움이 될 것이라고 전했습니다.
















중국 밖에서 신종 코로나바이러스 자체를 복제한 것은 이번이 처음입니다. 중국은 신종 코로나바이러스의 유전자 지도를 공유하기는 했으나, 바이러스 그 자체를 제공하진 않았습니다. 도허티 연구소의 줄리언 드루스 바이러스 식별 실험실 실장은 “실재 바이러스를 갖게 돼, 모든 진단 방법 등을 실제로 입증·확인할 수 있게 됐으며, (각 방법들의) 민감도와 특이성 등을 비교할 수 있게 됐다”고 의미를 부여했습니다.
호주 연구진의 신종 코로나바이러스 복제로, 무증삼 감염자를 걸러낼 수 있는 초기 진단에 도움이 될 것이란 전망이 나오고 있습니다. 앞서 크리스 린트마이어 세계보건기구 대변인은 28일(현지시각) 신종 코로나바이러스 감염증과 관련, 무증상 감염자도 바이러스를 옮길 가능성이 있다고 밝힌 바 있습니다.

다만 “우리가 지금까지 현장에 있는 의료진으로부터 알아낸 것은 잠복기가 1∼14일이라는 점”이라며 “감염자가 어느 정도 수준의 증상을 보여야 신종 코로나바이러스를 전파할 수 있는지는 단정할 수 없다”고 설명했습니다. 이와 관련, 연구진은 이 복제본이 감염 검사를 위한 ‘통제 물질’로 이용될 수 있으며 “진단에 있어서 ‘게임 체인저’(상황 전개를 획기적으로 바꿔놓을 발견)가 될 것”이라고 말했습니다.
캐턴 박사는 “항체 검사를 통해 역으로 감염 의심환자들이 어떻게 이 바이러스를 받아들이게 됐는지 파악할 수 있어, 바이러스가 어떻게 확산됐는지 더 정확한 그림을 그릴 수 있다”고 설명했습니다. 캐턴 박사는 이를 통해 “임상시험용 백신의 효율성을 평가하는 데도 도움이 될 것”이라고 덧붙였습니다.